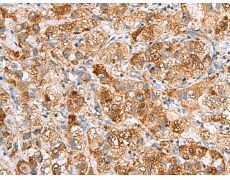
一抗

中文名稱: 兔抗NMU多克隆抗體
英文名稱: Anti-NMU rabbit polyclonal antibody
別 名: neuromedin U
相關(guān)類別: 一抗
儲 存: 冷凍(-20℃)
宿 主: Rabbit
抗 原: NMU
反應(yīng)種屬: Human
標(biāo) 記 物: Unconjugate
克隆類型: rabbit polyclonal
技術(shù)規(guī)格
|
Background: |
This gene encodes a member of the neuromedin family of neuropeptides. The encoded protein is a precursor that is proteolytically processed to generate a biologically active neuropeptide that plays a role in pain, stress, immune-mediated inflammatory diseases and feeding regulation. Increased expression of this gene was observed in renal, pancreatic and lung cancers. Alternative splicing results in multiple transcript variants encoding different isoforms. Some of these isoforms may undergo similar processing to generate the mature peptide. |
|
Applications: |
ELISA, IHC |
|
Name of antibody: |
NMU |
|
Immunogen: |
Fusion protein of human NMU |
|
Full name: |
neuromedin U |
|
SwissProt: |
P48645 |
|
ELISA Recommended dilution: |
5000-10000 |
|
IHC positive control: |
Human liver cancer |
|
IHC Recommend dilution: |
100-300 |

 購物車
購物車 幫助
幫助
 021-54845833/15800441009
021-54845833/15800441009